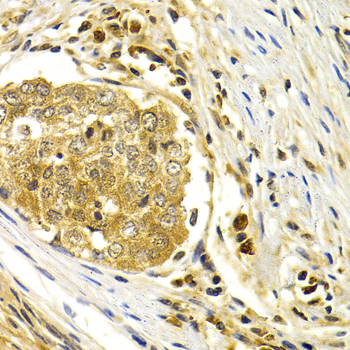

For quotations, please use our online quotation form, and you may also contact us by
service@kendallscientific.com
+1-888.733.6849 (Toll-free)
+1-617.299.7367 (Int’l))
+1-888.733.6849
Our customer service representatives are available 24 hours, Monday through Friday to assist you.| Reactivity | Human Mouse Rat |
| Tested applications | WB IHC IF |
| Recommended Dilution | WB 1:500 - 1:2000 IHC 1:50 - 1:200 IF 1:50 - 1:200 |
| Calculated MW | 39kDa |
| Observed MW | Refer to Figures |
| Immunogen | Recombinant protein of human CDK7 |
| Storage Buffer | Store at -20℃. Avoid freeze / thaw cycles. Buffer: PBS with 0.02% sodium azide, 50% glycerol, pH7.3. |
| Concentration | e |
| Synonym | CAK1; HCAK; MO15; STK1; CDKN7; p39MO15; |

Western blot analysis of extracts of mouse heart cells, using CDK7 antibody.

Immunohistochemistry of paraffin-embedded mouse brain using CDK7 antibody at dilution of 1:200 (400x lens).

Immunohistochemistry of paraffin-embedded human normal colon using CDK7 antibody at dilution of 1:200 (400x lens).

Immunohistochemistry of paraffin-embedded human normal stomach using CDK7 antibody at dilution of 1:200 (400x lens).

Immunohistochemistry of paraffin-embedded human stomach cancer using CDK7 antibody at dilution of 1:200 (400x lens).
Immunohistochemistry of paraffin-embedded human esophagus cancer using CDK7 antibody at dilution of 1:200 (400x lens).

Immunofluorescence analysis of U20S cell using CDK7 antibody. Blue: DAPI for nuclear staining.
CDK-activating kinase (CAK) is a complex of CDK7 and cyclin H. The complex is involved in cell cycle regulation by phosphorylating an activating residue in the T-loop domain of cdks (1). Regulation of CAK activity is mediated by T-loop phosphorylation and by association with MAT1, both of which enhance its kinase activity toward the CTD of RNA polymerase II (2,3) and other substrates such as p53 (4). CAK is an essential component of the transcription complex TFIIH and may interact directly with TFIIH helicases (5).
N/A